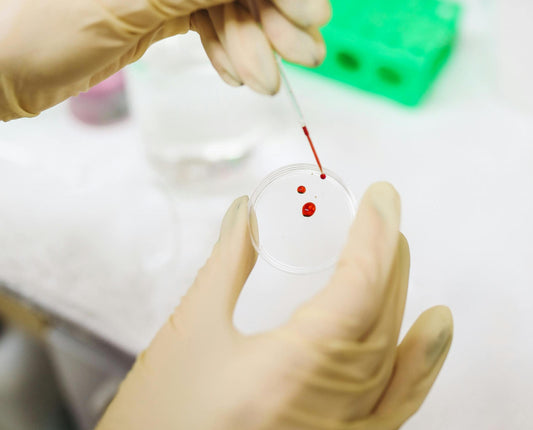

Der fembites Zykluswissen Blog

Wie Keranat™ deine Haare stärkt und Haarausfall stoppt
In diesem Artikel erfährst du, warum Haare ausfallen und wie du mithilfe von Keranat™ deine Haare stärken und Haarausfall stoppen kannst.
Weitere Artikel aus unserem Blog
Neuer Bluttest für die Diagnose von Endometriose
Der neue PromarkerEndo Test könnte der Schlüssel zu einer einfacheren Diagnose von Endometriose sein. Hier erfährst du, wie der Test genau funktioniert.
Neuer Bluttest für die Diagnose von Endometriose
Der neue PromarkerEndo Test könnte der Schlüssel zu einer einfacheren Diagnose von Endometriose sein. Hier erfährst du, wie der Test genau funktioniert.

Endometriose: Mythen vs. Fakten
In diesem Artikel befassen wir uns mit Endometriose Symptomen, Ursachen, der Diagnose und Behandlung auf und räumen mit gängigen Fehlinformationen auf.
Endometriose: Mythen vs. Fakten
In diesem Artikel befassen wir uns mit Endometriose Symptomen, Ursachen, der Diagnose und Behandlung auf und räumen mit gängigen Fehlinformationen auf.

Aminosäuren als Grundbaustein für Keratin und s...
Hier erfährst du, welche Aminosäuren wichtig für deine Haare sind, wie du sie aufnehmen kannst und welche weiteren Nährstoffe dein Haarwachstum unterstützen.
Aminosäuren als Grundbaustein für Keratin und starke Haare
Hier erfährst du, welche Aminosäuren wichtig für deine Haare sind, wie du sie aufnehmen kannst und welche weiteren Nährstoffe dein Haarwachstum unterstützen.

Wie Keranat™ deine Haare stärkt und Haarausfall...
In diesem Artikel erfährst du, warum Haare ausfallen und wie du mithilfe von Keranat™ deine Haare stärken und Haarausfall stoppen kannst.
Wie Keranat™ deine Haare stärkt und Haarausfall stoppt
In diesem Artikel erfährst du, warum Haare ausfallen und wie du mithilfe von Keranat™ deine Haare stärken und Haarausfall stoppen kannst.

Perimenopause: Alles was du wissen musst
Unsere Expertin Christiane Dölz, Ernährungsmedizinerin und -wissenschaftlerin, gibt Antworten auf alle Fragen rund um die Perimenopause. Sie verrät, welche Nährstoffe jetzt besonders wichtig sind, wie du deinen Hormonhaushalt mit der...
Perimenopause: Alles was du wissen musst
Unsere Expertin Christiane Dölz, Ernährungsmedizinerin und -wissenschaftlerin, gibt Antworten auf alle Fragen rund um die Perimenopause. Sie verrät, welche Nährstoffe jetzt besonders wichtig sind, wie du deinen Hormonhaushalt mit der...

Mittelschmerz: Warum tut der Eisprung weh – und...
Viele Frauen erleben rund um ihren Eisprung das Phänomen Mittelschmerz. Hier erfährst du, was Mittelschmerz ist, wie er entsteht und wie du ihm begegnen kannst.
Mittelschmerz: Warum tut der Eisprung weh – und was hilft?
Viele Frauen erleben rund um ihren Eisprung das Phänomen Mittelschmerz. Hier erfährst du, was Mittelschmerz ist, wie er entsteht und wie du ihm begegnen kannst.
Bleibe auf
dem Laufenden
Erhalte unseren Newsletter über Gesundheit, Ernährung & Rabattaktionen.
Abmeldung jederzeit möglich.
Folge uns
bei Instagram
40.000+ Follower*innen